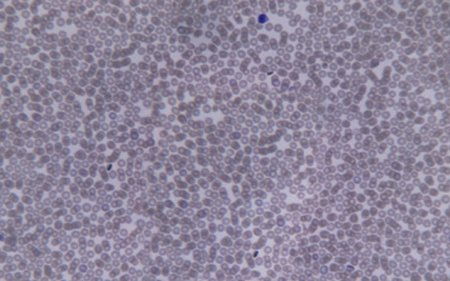
Újabb remény a rák ellen

Hírek
2013. Január 05. 05:00, szombat |
Belföld
Forrás: OrientPress Hírügynökség
Újabb remény a rák ellen
Olyan nagyszámú sejteket fejlesztettek ki laboratóriumi kereteken belül, amelyek hatékonyan vették fel a harcot a rák és a HIV-fertőzés ellen, így potenciális kezelésként lehetne őket alkalmazni a betegségek ellen - írja a BBC. Ezek a sejtek normálisan alacsony számban vannak jelen, de a szakemberek szerint, hogyha nagy számban juttatják be azokat a páciens szervezetébe, az felturbózhatja az immunrendszert.
Szakértők szerint az eredmények ígéretesek, azonban még további vizsgálatok szükségesek ahhoz, hogy a kezelést biztonságosan alkalmazhassák. A kutatók vizsgálatukban az egyik, citotoxikus T-sejt nevű fehérvérsejtre koncentráltak, amelyek képesek felismeri a sejteken a fertőzések és a rák árulkodó jeleit.
A Tokyo Egyetem és a Riken Allergia és Immunilógiai Kutató Központ kutatói őssejtterápiát alkalmaztak több T-sejt előállítására. Az egyik csoport tagjainál a bőrrákot, a másiknál a HIV-fertőzést célozták meg.
A vizsgálatok csupán azt bizonyították, hogy elő tudják állítani az említett sejteket, azt egyelőre nem, hogy biztonságosan visszajuttatható a páciensek szervezetébe.
Dr. Hiroshi Kawamoto, aki a bőrrákos csapaton dolgozott, elmondta: 'A következő lépés, hogy megnézzük, hogy ezek a T-sejtek képesek-e szelektíven megölni kizárólag a rákos sejteket, anélkül, hogy az egészséges sejteket károsítsák. Hogyha igen, ez a jövő rákkezelésének hatékony módja lehet.' Hasonlókat mondott Dr Hiromitsu Nakauchi, a Tokyo Egyetem kutatója, aki szerint még nem egyértelmű, hogy a technika hatékony-e a HIV kezelésére.
A szakértők szerint azonban az eredmények biztatóak. Mivel a sejteket minden pácienshez egyénileg hozzá lehetne igazítani, így nem állna fenn a kilökődés veszélye sem. Ugyanakkor ha be is bizonyosodik a technika hatékonysága, még egy probléma felvetődik: a T-sejteket ugyanis nagy mennyiségben nehéz előállítani biztonságosan és gazdaságosan egyaránt.
Ezek érdekelhetnek még
2026. Június 21. 16:00, vasárnap | Belföld
MÁV: Elindult a nyári főszezoni menetrend
Kétszer annyi vonat közlekedik a Balatonhoz június 20-án induló nyári főszezonban mint eddig, az ülőhelyek száma pedig megháromszorozódik a nyári csúcsforgalomban
2026. Június 21. 14:00, vasárnap | Belföld
Sulyok Tamás jelezte, hogy jogi eszközök alkalmazásával is ellenáll az eltávolítását célzó erőfeszítéseknek
2026. Június 21. 11:00, vasárnap | Belföld
Hegedűs Zsolt: a jövő héten publikálják az orvosok közösségi médiahasználatának etikai szempontjairól szóló állásfoglalást
Elkészült, a jövő héten publikálják az orvosok közösségi médiahasználatának és nyilvános online egészségügyi kommunikációjának etikai szempontjairól szóló állásfoglalást
2026. Június 21. 10:28, vasárnap | Belföld
Múzeumok éjszakája - Magyar Péter: a magyar közlekedés végre új lendületet kaphat
Vitézy Dávid közlekedési és beruházási miniszter vezetésével a magyar közlekedés végre új lendületet kaphat - mondta Magyar Péter miniszterelnök a Közlekedési Múzeum új időszaki kiállításának megnyitóján szombaton.
